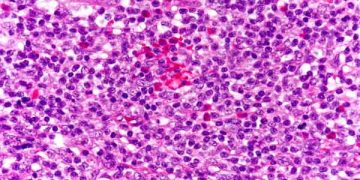
Yalancı Lenfom Nedir?

Yalancı Lenfom, böcek veya eklembacaklı ısırması veya aşılamaların sonrasında gelişen lenfosit ve plazma hücrelerinden oluşan lenfomlarla karıştırılabilen yangılı tepkimesine denir. ...
Read moreDetailsVetRehberi, Veteriner Hekimlik mesleği, hayvan sağlığı, hayvan hastalıkları, hayvan beslenmesi, hayvan ırkları, ebooks, sözlük, veteriner ilaçlar, yaban hayatı hakkında içerik yayınlayan ve soru-cevap ile hayvanlarınızın sorunlarına cevap veren bilgi platformudur.